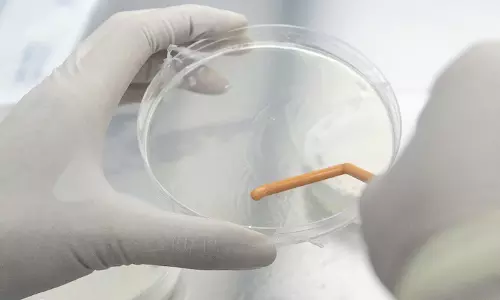
HMPV Cases in India

Home > hmpv virus
You Searched For "HMPV Virus"
HMPV Virus: భారత్ లో తొలి HMPV వైరస్ ఫస్ట్ నమోదు.. వైద్య, ఆరోగ్యశాఖ అలర్ట్ 6 Jan 2025 4:45 AM GMT
HMPV Virus Outbreak: మాస్క్ పెట్టుకోండి, చేతులు కడుక్కోండి, షేక్ హ్యాండ్స్ మానేయండి 5 Jan 2025 8:52 AM GMT
HMPV Virus: చైనాలో పిల్లులకు కొత్త వైరస్..కోవిడ్ మాత్రలు వేస్తున్న యజమానులు 5 Jan 2025 2:09 AM GMT
HMPV Virus: చైనాను వణికిస్తున్న కొత్త వైరస్ హెచ్ఎంపీవీ.. ఎంత ప్రమాదమో తెలుసా? 3 Jan 2025 9:39 AM GMT
About
HMTV team aims to keep you abreast with whatever is making headlines across the world including politics, business, sports, lifestyle and entertainment.
Our Links
Subscribe
Get the best positive stories straight into your inbox!
SubscribeSubscribed Failed...
Subscribed Successfully...
We're social, connect with us:
© Copyrights 2025. All rights reserved.
Powered By Hocalwire